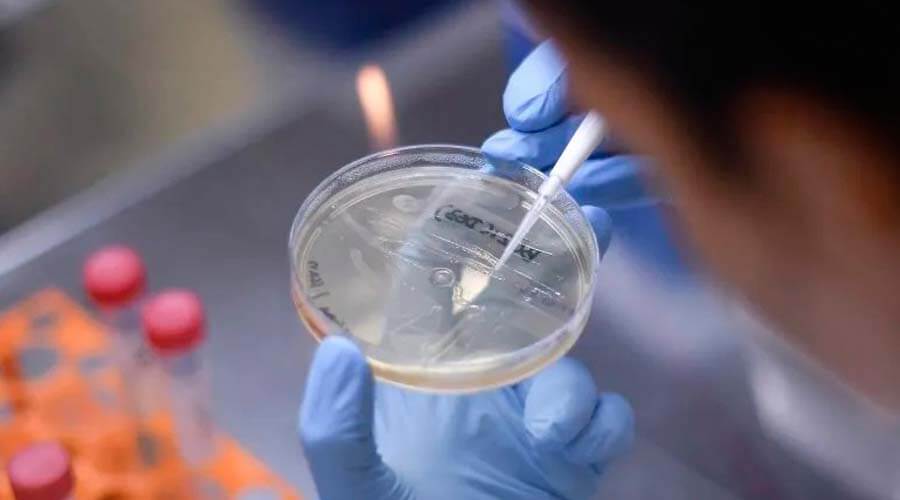

Brasil registra nueva jornada de protestas contra Bolsonaro
Desde que empezó la pandemia en Brasil, a la que llegó a considerar una "gripecita", el mandatario Jair Bolsonaro ha criticado las medidas de cuarentena Decenas de miles de personas volvieron a manifestar en varias ciudades de Brasil contra el presidente Jair Bolsonaro, en especial por su gestión de la pandemia,
Leer Más